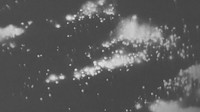

Einleitung
Dresden 13. Februar 1945Alltag des Krieges oder Kriegsverbrechen?
der Sächsischen Zeitung
Von Oliver Reinhard und Fabian Deicke
Erstellt im Februar 2015
Aktualisiert im Februar 2023
Warum "Dresden"?
Kurz darauf kam über die Stadt das größte Inferno ihrer Geschichte. Die Bomben vernichteten das eng bebaute Zentrum und richteten in umliegenden Stadtteilen enorme Verwüstungen an. Durch die Innenstadt tobte ein Feuersturm. Bis zu 25 000 Menschen wurden erschlagen, erstickten in Kellern, verglühten in den Flammen. Als sich die zweite Bomber-Welle näherten, konnten deren Besatzungen den Schein der Katastrophe schon von Weitem ausmachen: Dresden selbst war zum roten Leuchten geworden.
"Du kannst es Dir nicht vorstellen, es ist alles einfach weg!" Das schrieb eine Dresdnerin unmittelbar nach den schweren Bombenangriffen vom 13. und 14. Februar 1945 auf ihre Stadt an eine Freundin. In ihren Worten spiegeln sich das ganze ungläubige Staunen, das Entsetzen und die Fassungslosigkeit der Menschen in der zerstörten Elbmetropole. Was sie durch- und mitgemacht hatten oder danach in ihren sichtbaren Auswirkungen betrachteten, war nicht nur die schwerste Katastrophe in der Lokalhistorie. Vielmehr ist die Vernichtung weiter Gebiete der alten und für ihre Schönheit gerühmten sächsischen Hauptstadt ein in mehrfacher Hinsicht einzigartiges Ereignis in der Geschichte des 20. Jahrhunderts.
Dresden von 1933 bis 1944/45
2. Trügerischer Frieden
Dresden ist nicht nur eine Stadt, Dresden ist eine Weltanschauung. So lautet schon vor über 100 Jahren das Selbstverständnis der Bürger. Die alte Residenz ist weithin berühmt für ihre Schönheit, ihre Kultur, ihre Kunstschätze. Unzählige Besucher erleben sie und ihre Bewohner
als weltoffen und geistvoll.
Dennoch gewinnt auch hier in den Zwanzigerjahren der Nationalsozialismus an Boden. Bei der Reichstagswahl
im November 1932 votieren knapp 34 Prozent der Bewohner für Adolf Hitler. Damit ist Dresden unter den deutschen Städten ihrer Größe jene mit den meisten
NSDAP-Stimmen nach Breslau. Die Weichen sind gestellt.
Nach der "Machtergreifung" am 30. Januar 1933 machen sich Gauleiter Martin Mutschmann und seine Getreuen daran, Sachsen in ein braunes Vorzeigeland zu verwandeln.
Brutal gehen sie gegen Angehörige von KPD und SPD vor, sperren sie ein, verbieten deren Parteien. Es kommt
zu Boykottaufrufen gegen jüdische Geschäfte, zu Zwangs-"Arisierungen", zur Entlassung jüdischer Angestellter.
1938 brennt Dresdens Synagoge. Missliebige Künstler wie
der Staatsopern-Generalmusikdirektor Fritz Busch oder die Kunstprofessoren und Maler Otto Dix und Oskar Kokoschka werden vertrieben, man organisiert die erste Ausstellung "entarteter" Kunst.Als Zeichen dafür, dass Dresden auch unter den Nazis eine deutsche Kulturmetropole bleiben soll,
kürt Hitler sie zum Ort der ersten Reichstheaterwochen.
Dresden im Luftkrieg
3. Dresden im LuftkriegTOD VOR DEN TOREN DER STADT
einen ersten Dämpfer: US-Bomber greifen das Mineralölwerk Rhenania Ossag in Freital an, kurz vor den Toren der Stadt. 241 Menschen sterben. Die Dresdner reagieren erschrocken und entsetzt, aber nicht wirklich beunruhigt. Die meisten bewerten den Angriff als Versehen.
Das nächste "Versehen“ lässt nur sechs Wochen auf sich warten. Am 7. Oktober bombardieren 29 amerikanische "Fliegende Festungen“ den Friedrichstädter Bahnhof.
Sie treffen auch das Innenstadtgebiet. Es gibt 267 Tote,
45 davon auf dem Gelände des Rüstungswerkes Seidel & Naumann. Drei Monate darauf, am 16. Januar 1945, erfolgt ein weiterer Schlag auf das Stadtgebiet. Immer weniger Menschen glauben nun noch an Versehen oder Zufälle. Viele ahnen,
dass es nicht bei diesen kleineren Angriffen bleiben wird.
"Jeden Abend hörten wir die Luftlagemeldungen im Radio", erzählt Nora Lang. "Und wir fragten uns: Wann wird es Dresden treffen?" Bald sollten sie darauf eine Antwort bekommen.
Im Westen überschreiten alliierte Verbände die Grenze
des Reiches, im Osten nähert sich die Rote Armee Frankfurt
an der Oder und Breslau. Der Krieg ist für Deutschland verloren. Doch es kämpft weiter. Aus Fanatismus,
aus Gehorsam, aus Ratlosigkeit und Angst vor der Rache der Sieger. Auch in Dresden wird diese Angst noch geschürt durch Berichte über Gräueltaten der Roten Armee, erzählt von Ostflüchtlingen, die zu Zehntausenden die Stadt erreichen, zumeist nur kurz bleiben und dann weiterziehen.
Propaganda - Erinnerung - Gedenken
4. Vom Erinnern zum Gedenken
Alljährlich im Winter sinkt Dresdens neuer Glanz in den Schatten eines einzigen Datums: In den Tagen um den
13. Februar sorgen Nationalisten und Rechtsextremisten
aus ganz Europa, die sich hier versammeln, international
für Schlagzeilen. Sie missbrauchen die Katastrophe
von 1945 für einen revanchistischen "Trauermarsch“ anlässlich des "alliierten Bomben-Holocausts“.
Tausende Gegendemonstranten stellen sich ihnen entgegen. Mittendrin und dazwischen: die Dresdner selbst. Drumherum: ein Land, das den Kopf schüttelt. Haben nicht andere Städte genauso gelitten unter den Bomben? Warum nur all das Dresdner "Theater“ um den 13. Februar?
Weil der 13. Februar auch eine Art Gefühl ist. Das Gefühl
der "Wunde Dresden“. Wie in anderen deutschen Städten auch schlug zwar der gleiche Krieg diese Wunde.
Doch nirgends wurde vergleichbar früh, nachhaltig und weltweit dafür gesorgt, dass sie nicht verheilen konnte.
Kunst und Debatten
5. Kunst und Gedenken
Nicht erst seit Überführung des ersten Nagelkreuzes aus Coventry 1965 haben sich Künstler aus anderen Ländern mit Geschichte, Bedeutung, Vermächtnis der Tragödie beschäftigt. Spätestens mit Erscheinen des Romans „Schlachthof 5“ des Amerikaners Kurt Vonnegut im Jahr 1969 war „Dresden“ endgültig nicht länger nur Chiffre für die konkreten Schrecken des Luftkriegs über. Es wurde darüber hinaus zum Symbol für militärische Gewalt gegen Zivilisten überhaupt. In Dresden ebenso wie in Vietnam, in Afghanistan, im Irak, auf dem Balkan – oder wie jüngst in Syrien.
Zusammen mit Bürgern der Stadt senden Künstler aus unzähligen Ländern bis heute Zeichen der Versöhnung und des Friedenswillens in alle Welt. Sie tun dies in Form von Literatur, Konzerten, Theaterprojekten, Gemälden, Performances, Skulpturen, Filmen. Oft unter Beteiligung von Überlebenden des 13. Februar. Etwa beim Projekt „Gravuren“, mit denen besondere Orte des 13. Februar gekennzeichnet werden, beim Hellerauer Tanzstück „The Past“ von Constanza Macras, bei Paule Savianos auch in Tokyo präsentierter Fotoschau „From Above“.
Sorgen der Kritiker
Der Protest gegen das Kunstwerk fällt in eine Zeit, in der auch Dresdens Oberbürgermeister Hilbert unter Polizeischutz steht. Er hatte Morddrohungen erhalten wegen seiner Wiederholung der historischen Erkenntnis: „Dresden war keine unschuldige Stadt.“ Manche Kritiker drehen ihm das Wort um und behaupten, damit habe Hilbert automatisch gesagt, Dresden sei „eine schuldige Stadt“. Tatsächlich lagen Schuld und Unschuld wie überall auch in Dresden sehr eng beieinander.
Hilberts Satz und der bei einigen Dresdnern spürbare tiefen Unwillen, dem Gedenken an den 13. Februar 1945 eine Bedeutung zuzugestehen, die über das konkrete historische Ereignis hinausreicht, sind Hinweise auf die Ursache des Protests. Zudem haben sich auch in Dresden gewisse politische Interessengruppen formiert, die wie bereits vor Jahren die NPD registriert haben, wie gut sich mit nationalen Thesen zur Vergangenheit bis hin zum offenen Revisionismus im Wahljahr punkten lässt. Etwa damit, dass man „Dresden 1945“ wieder aus seinen historischen Zusammenhängen löst, um es damit erneut als weltweite „Einzigartigkeit“ herauszustellen.
Eine zentrale Sorge der Kritiker lautet, das konkrete Gedenken an die Dresdner Opfer des 13. Februar 1945 könne durch Aktionen wie das Bus-„Monument“ oder die zeitgleiche Kunstinstallation sizilianischer Flüchtlingsgräber auf dem Theaterplatz marginalisiert werden und irgendwann aus dem Blick geraten.
Eine Sorge, für die es seit 1965 bisher jedoch keinen konkreten Anlass gegeben hat: Seit dem Nagelkreuz nehmen sämtliche Kunstaktionen dezidiert Bezug auch auf Dresdens Luftkriegstote. Sie spielen deren Vermächtnis nicht herunter. Sie sorgen im Gegenteil dafür, dass sie – nicht nur in Dresden – niemals aus dem öffentlichen Gedächtnis verschwinden.
Ausblick
Wie geht das Gedenken weiter?
Seit dem ersten gezielten Flächenbombardement auf Zivilisten, dem Angriff der deutschen "Legion Condor“
1937 auf Guernica, nahmen die Bomben-Strategien immer hemmungslosere Formen an. Warschau, Coventry, London, Leningrad, Hamburg, Dresden, Hiroshima, Nagasaki, Bagdad, Damaskus, Grosny - nur im Zusammenhang erzählen diese Namen die Geschichte der schrittweisen Entgrenzung
des Luftkriegs, der am Ende nur ein Ziel hat: die Zerstörung, vor allem von Menschenleben. Dresden war einer der letzten Schritte in jene Ära, die diese Form von Massentötungen
aus der Luft perfektioniert hat: das Atomzeitalter.
Eindeutige Zuschreibungen von Täter- und Opferschaft im Krieg greifen nicht mehr. Zu oft ist beides untrennbar miteinander verwoben. Auch diese Erkenntnis gehört zur großen Erzählung vom 13. Februar 1945 in Dresden.
Dresden 13. Februar 1945Alltag des Krieges oder Kriegsverbrechen?
der Sächsischen Zeitung
Idee, Konzept, inhaltliche und technische Umsetzung:
Oliver Reinhard
Fabian Schröder
Filme und Bilder:
Hirsch Film Dresden
Stadtarchiv Dresden
Fotothek der SLUB Dresden
Sächsisches Staatsarchiv – Hauptstaatsarchiv Dresden
National Archives (USA)
Danksagung:
Wir danken Ernst Hirsch für seine großzügige Unterstützung und Hilfe, Nora Lang und Lothar Liebelt für ihre Erinnerungen, dem Team des Dokfilms "Come Together" (Claudia Jerzak, Barbara Lubich und Michael Sommermeyer von Hechtfilm) sowie dem Hilton-Hotel Dresden.
Ebenso gilt unser Dank Christina Wittich für Tonaufnahmen und MoPo24 für die Bereitstellung ihres Studios.
© sz-online/Sächsische Zeitung
Zusatzmaterial
Die Sucht des Bombardierens
Herr Taylor, laut Ihrer Forschungen war Dresden ein legitimes militärisches Ziel. Nicht nur unter vielen Dresdnern ist die Empörung groß. Worauf gründen Sie Ihre Behauptung?
Zum einen möchte ich sagen, dass ich durchaus nicht der erste bin, der dieses feststellt. Tatsächlich befand sich in Dresden eine der größten deutschen Garnisonen, war die Stadt ein wichtiger Verkehrsknotenpunkt war. Außerdem haben hier wie in allen Städten des Reiches die meisten Betriebe im Verlauf des Krieges direkt oder indirekt für die Rüstung produziert. Das mussten sie ja auch, schließlich hatte Goebbels 1943 den Totalen Krieg ausgerufen. Sogar Schokoladenfabriken oder Schreibmaschinenhersteller hatten ihre Produktion entsprechend umgestellt.
Aber als Industriestandort konnte es die Stadt an Bedeutung doch nicht mit etwa Duisburg oder Essen aufnehmen?
Dort gab es vor allem Schwerindustrie, in Dresden war mehr die leichtere Industrie angesiedelt, die feinmechanische, elektronische und optische Güter für den Krieg herstellte. Darunter Zielgeräte und Granatzünder. Allein in den Zeiss-Werken arbeiteten 14 000 Menschen direkt für die Rüstung. Und vergessen Sie nicht das große Sachsen-Werk. Es ist auch so, dass ab Herbst 1944 die meisten Industriebetriebe aus stark luftgefährdeten Gebieten in das vermeintlich sichere Dresden verlegt wurden. Es ist mir wichtig, darauf hinzuweisen, dass Dresden im Krieg eben nicht nur die Kunst- und Kulturstadt war, als die sie immer noch von so vielen betrachtet wird.
Trotzdem haben die britischen Verbände am 13. und 14. Februar das Stadtzentrum zerstört, wo es kaum militärisch relevante Objekte gab. Im Zielgebiet der Bomber lag nicht einer der 18 Dresdner Bahnhöfe, ebenso wenig die Garnison.
Hierin werde ich mit meinem Buch leider oft missverstanden, auch von vielen Dresdner Lesern. Ich sage lediglich, dass die Stadt ein legitimes militärisches Ziel war, aber nicht, dass die britischen Angriffe auch militärischen Zielen gegolten haben. Sie sollten die Zivilbevölkerung treffen. Das macht sie ja gerade so furchtbar und schockierend. Und ich wünsche mir, sie hätten niemals stattgefunden.
Die alliierten Flächenbombardements haben sich durchaus kriegsverkürzend ausgewirkt. Abgesehen von den Zerstörungen, die sie verursachten, haben sie zehntausende Menschen für Aufräum- und Instandsetzungsarbeiten gebunden, die in der Produktion und an der Front fehlten. Gab es noch andere Gründe?
Durchaus, und zwar, wenn man so will, ökonomische. Sie müssen wissen, dass die Flächenbombardements ja eine Form des Zermürbungskriegs waren ...
1944 war den Alliierten klar, dass die Deutschen sich damit nicht zermürben ließen. Die Amerikaner haben die Briten sogar gedrängt, diese Art der Kriegsführung einzustellen und sich stattdessen auf militärische und industrielle Ziele zu konzentrieren.
Das stimmt. Aber schauen Sie: 1944 verfügten die Briten über eine sehr große und teure Bomberflotte und für Flächenbombardements ausgebildete Besatzungen. Den Angriff auf im Vergleich zu einem Stadtzentrum kleinere militärische Ziele beherrschten sie weniger gut.
War es schwieriger und gefährlicher, solche Punktziele anzugreifen?
Es war wesentlich problematischer. Außerdem lagen solche Ziele ja oft in Wohngebieten, manche waren extra dorthin verlegt worden. Und der Oberbefehlshaber der britischen Bomber, Arthur Harris, wollte unbedingt an der einmal eingeschlagenen Strategie festhalten. Also ließ man die schreckliche und letztlich wahllose Vernichtungsmaschinerie weiterlaufen. Das Erschütternde ist, dass auf allen Konferenzen der Alliierten niemand auch nur erwähnte, wie furchtbar diese Strategie eigentlich ist. Auch an der Spitze des britischen Bomberkommandos standen eben nur kühle Technokraten. Außerdem: Warum sollte man nun noch einmal Städte wie Essen oder Dortmund angreifen, die waren doch längst zerstört. Also suchte man sich nun unzerstörte Städte aus - wie Dresden. Und ich denke auch, dass sich die Briten gerade von der Zerstörung dieser berühmten und bislang verschonten Stadt eine hohe moralische Wirkung auf die Deutschen erhofften. Ich habe lange nach einem wirklich stichhaltigen strategischen Grund für die Zerstörung des Stadtzentrums gesucht. Ich habe keinen gefunden.
Waren die britischen Angriffe in Ihren Augen ein Kriegsverbrechen?
Schwer zu sagen, ich weiß es nicht genau. Ich würde aber sagen, sie lagen mindestens an der Grenze zum Kriegsverbrechen, wie alle Flächenbombardements. Doch man muss beim Blick auf diese Vergangenheit sehr genau zwischen den verschiedenen Vorkommnissen unterscheiden. Es ist zwar heute populär, die deutschen Angriffe auf Guernica, Warschau und Coventry als absichtliche Terror-Bombardements zu bezeichnen. Das waren sie aber nicht, denn sie galten militärischen Zielen. Die beiden britischen Attacken auf Dresden dagegen galten vornehmlich der Zivilbevölkerung. Nur - streng genommen stellten auch sie nach den damals gültigen und noch sehr vagen Bestimmungen des Völkerrechts keine Verbrechen dar. Aus heutiger Sicht und nach heute geltendem Völkerrecht jedoch müsste man sie als Verbrechen bezeichnen.
Entsprachen die Angriffe dem damals üblichen Denken und der Logik der Militärs?
Unbedingt. Ich fürchte auch, dass sich daran nicht allzu viel geändert hat. Wenn Militärs einmal die Mittel haben, möglichst viele Gegner umzubringen, dann setzen sie diese Mittel auch ein. Ob es sich bei den Opfern um Soldaten oder Zivilisten handelt, macht für sie, so denke ich, keinen wesentlichen Unterschied mehr.
Diese These beziehen Sie also auch auf die Kriege der Gegenwart?
Es ist doch so: Das Beispiel des Zweiten Weltkrieges und seiner Nachgeschichte hat uns in meinen Augen gezeigt, dass die Briten und Amerikaner eine gewisse Sucht nach dem Bombardieren entwickelt haben. Es hält die Verluste in den eigenen Reihen niedrig und hat bei relativ geringem Aufwand und geringen Kosten eine vergleichsweise große Wirkung. Das haben uns die Bombardements in Afghanistan und Irak gezeigt. Aber es ist doch nachweislich der falsche Weg, Konflikte zu lösen, und ganz gewiss nicht der richtige Weg in die Zukunft. Ich persönlich halte das Bombardieren aus der Luft für das verwerflichste Mittel überhaupt, um einen Krieg zu führen. Die Dresdner haben ganz andere Lehren aus ihrer Geschichte gezogen. Ich habe sie hier auch immer wieder von vielen Menschen vernommen: Man muss alles dafür tun, dass sich so etwas niemals und nirgendwo wiederholen kann.
Gespräch: Oliver Reinhard
Chronik der neun Angriffe auf Dresden und Umgebung
Im Rahmen der alliierten Öl-Offensive fliegen drei US-Bombergruppen Angriffe auf Treibstoffproduktions-Zentren in Mitteldeutschland. Ein Verband von 62 B 17-Bombern ist auf das Mineralölwerk der Rhenania-Ossag in Freital angesetzt. Um 12.59 Uhr wirft er insgesamt 620 Bomben ab. Einige davon treffen das Ziel, die meisten aber den Ortsteil Birkigt und das Industriegelände Gittersee. 241 Menschen sterben.
7. Oktober 1944
Weil das Wetter über dem geplanten Ziel, dem sudetischen Brüx, zu schlecht ist, fliegen 29 US-Bomber B 17 zum zweiten Mal einen Angriff auf das "Ersatzziel" Dresden. Ab 12.34 Uhr werfen sie 50 Tonnen Sprengbomben ab und treffen damit den Friedrichstädter Verschiebebahnhof sowie Teile der Innenstadt zwischen Postplatz und Bahnhof Wettiner Straße. 267 Menschen sterben.
16. Januar 1945
127 amerikanische Bomber B 24 „Liberator“ erscheinen um 12.12 Uhr über Dresden. Ihr Ziel ist erneut der Bahnhof Friedrichstadt, doch die Bomben fallen weit verstreut und treffen u.a. die Stadtteile Cotta, Leutewitz, Löbtau sowie die westliche Innenstadt. 334 Menschen sterben.
13. Februar 1945
Am Nachmittag steigen britische Bomber in Südengland auf und nehmen Kurs auf Mitteldeutschland. Der erste von zwei Verbänden nähert sich spätabends mit 243 Lancaster-Bombern Dresden. Das Ziel der Maschinen ist diesmal ausschließlich die Innenstadt. Zwischen 22.03 Uhr und 22.28 Uhr werfen sie knapp 900 Tonnen Spreng- und Brandbomben ab. Weite Teile des historischen und eng bebauten Zentrums werden zerstört, in der Stadtmitte Dresdens tobt ein verheerender Feuersturm.
14. Februar 1945
Um 1.30 Uhr erscheint die zweite Angriffswelle mit 529 Lancastern über der Stadt. Sie erhalten den Befehl, das Zielgebiet auszuweiten. Über 1500 Tonnen Bomben schlagen in das Stadtgebiet von Löbtau bis Loschwitz, ebenso in den Großen Garten und die Elbwiesen, wohin sich viele Überlebende des ersten Angriffs gerettet haben.
14. Februar 1945, mittags
Um 12.17 Uhr greift ein Verband aus 311 amerikanischen B 17 an. Weil das Wetter schlecht ist, müssen die Bomber ihre Ladung von knapp 800 Tonnen Spreng- und Brandbomben nach Zielradar abwerfen, was zu Ungenauigkeiten und Fehlwürfen führt. Trotzdem treffen die meisten den Friedrichstädter Bahnhof, aber auch umliegende Wohngebiete und das Krankenhaus Friedrichstadt.
15. Februar 1945
Am Vormittag bricht die Frauenkirche in Folge schwerer Treffer zusammen. Anderthalb Stunden später, um 11.51 Uhr, fliegen 210 amerikanische B 17 einen erneuten Angriff auf Dresden. Wieder ist die Sicht schlecht, sodass ihre Ladung von 460 Tonnen verstreut auf das Stadtgebiet und die Umgebung fällt, auch auf Meißen und Pirna. Fast 80 Prozent des Wohnungsbestandes sind vernichtet. Die Behörden lassen einige Stadtteile abriegeln und zu „Toten Gebieten“ erklären.
2. März 1945
455 US-Bomber sollen die Hydrierwerke Ruhland und Schwarzheide angreifen. Wegen schlechtem Wetter nehmen sie Kurs auf ihr Ausweichziel Dresden, das sie um 10.27 Uhr erreichen. Fast 1100 Tonnen Bomben graben die Trümmerwüste noch einmal um.
17. April 1945
Da Dresden nun eines der wichtigsten verbliebenen Bahnverkehrszentren im noch unbesetzten Reichsgebiet ist, richtet sich der größte Angriff auf die Stadt durch 580 US-Bombern vor allem gegen den Bahnhof Friedrichstadt. Die Angreifer werfen insgesamt etwa 1 700 Tonnen Bomben ab. Der Bahnhof wird völlig zerstört und kann bis Kriegsende nicht mehr repariert werden. 450 Menschen sterben.
Filmbeiträge

Download: Bericht der Historikerkommission

des 13. Februar 1945. Auftraggeber der Kommission war die Stadt Dresden. Im Mittelpunkt der Analyse stand die Frage nach der Opferzahl der Bombenangriffe.
Klicken Sie zum Herunterladen auf das Dossier-Icon.
Dokumentationen im SZ-Shop

Neu ist die Reihe "Dresdner Filmschätze". Mehr Informationen dazu nach Klick auf das Dossier-Icon.







































































 Dresden 13. Februar 1945
Dresden 13. Februar 1945
 Eine unschuldige Stadt?
Eine unschuldige Stadt?
 Warum "Dresden"?
Warum "Dresden"?
 Nach dem Angriff
Nach dem Angriff
 Trauma einer Katastrophe
Trauma einer Katastrophe
 2. Trügerischer Frieden
2. Trügerischer Frieden
 Aufschwung und Abstieg
Aufschwung und Abstieg
 Nora Lang - Kindheit in der NS-Zeit
Nora Lang - Kindheit in der NS-Zeit
 Lothar Liebelt - Kindheit in der NS-Zeit
Lothar Liebelt - Kindheit in der NS-Zeit
 Krieg, Entbehrung, Zwang
Krieg, Entbehrung, Zwang
 Lebensmittel werden knapp
Lebensmittel werden knapp
 Zug für Zug in den Tod
Zug für Zug in den Tod
 Vorboten des Bombenkrieges
Vorboten des Bombenkrieges
 Dresden wird "kriegswichtig"
Dresden wird "kriegswichtig"
 Dresden 1933 - 1944
Dresden 1933 - 1944
 3. Dresden im Luftkrieg
3. Dresden im Luftkrieg
Der 13. Februar
Der 13. Februar
 Der 14. Februar
Der 14. Februar
 Bilanz des Schreckens
Bilanz des Schreckens
 Dresden 1944 - 1945
Dresden 1944 - 1945
 4. Vom Erinnern zum Gedenken
4. Vom Erinnern zum Gedenken
 Geburt eines Symbols
Geburt eines Symbols
 Nationaler Kampftag der DDR
Nationaler Kampftag der DDR
 "Bombenholocaust" oder Friedensruf?
"Bombenholocaust" oder Friedensruf?
 Dresden 1945 bis heute
Dresden 1945 bis heute
 5. Kunst und Gedenken
5. Kunst und Gedenken
 Aufstand um ein Monument
Aufstand um ein Monument
 Manaf Halbouni - "Symbol für Frieden"
Manaf Halbouni - "Symbol für Frieden"
 Sorgen der Kritiker
Sorgen der Kritiker
 Wie geht das Gedenken weiter?
Wie geht das Gedenken weiter?
 Dresden 13. Februar 1945
Dresden 13. Februar 1945
 Die Sucht des Bombardierens
Die Sucht des Bombardierens
 Filmbeiträge
Filmbeiträge
 Download: Bericht der Historikerkommission
Download: Bericht der Historikerkommission
 Dokumentationen im SZ-Shop
Dokumentationen im SZ-Shop